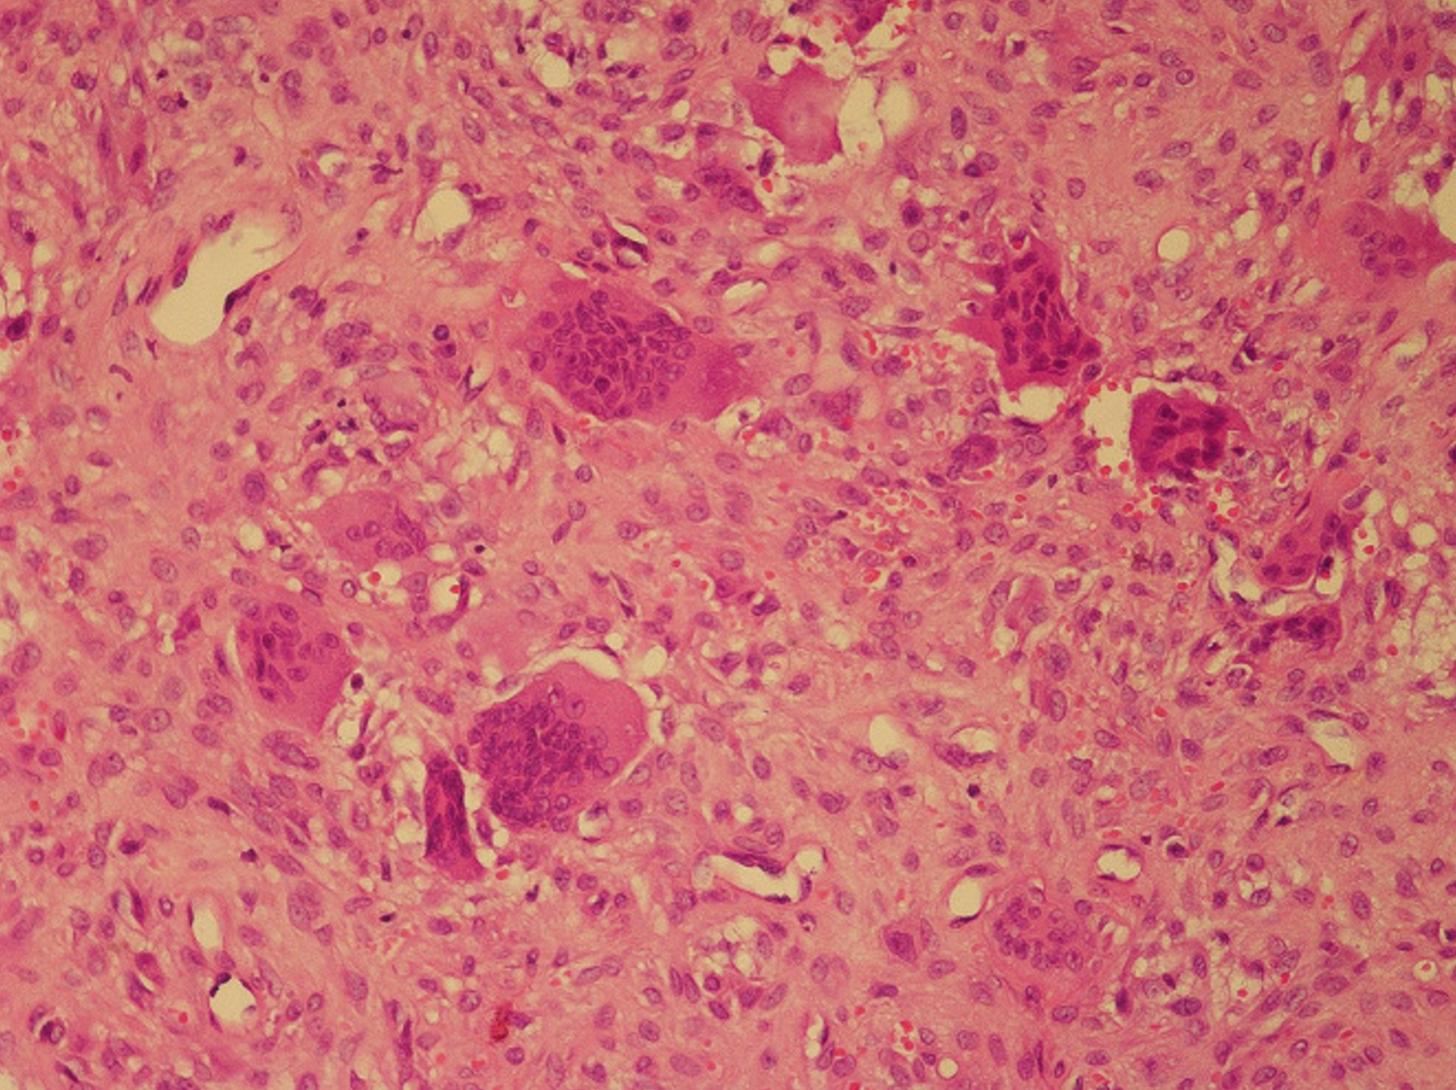

来源:医博士 | 2024-01-29
甲状旁腺激素(PTH)由甲状旁腺分泌,在钙和骨骼代谢中起着至关重要的作用。PTH的分泌主要受血清钙水平的调节。钙代谢是一个复杂的过程,涉及多种因素,相互作用紧密。PTH作为增强破骨细胞活性的刺激物,导致钙和磷的吸收。甲状旁腺激素还能激活肾脏中的维生素D。维生素D能增强胃肠道和肾脏对钙和磷的吸收,抑制甲状旁腺激素的分泌。成纤维细胞生长因子23(FGF-23)是一种由骨细胞分泌的激素,可抑制肾脏中维生素D的活化。
甲状旁腺功能亢进症可在所有年龄段发病,其特征有三种形式。原发性甲状旁腺功能亢进是由于甲状旁腺分泌过多甲状旁腺激素,其特征是高钙血症和血清磷水平下降。继发性甲状旁腺功能亢进症(SHPT)最常见于慢性肾脏疾病(CKD),其特征是高磷血症和钙离子水平下降。三发性甲状旁腺功能亢进症是长期SHPT后甲状旁腺自主过度分泌甲状旁腺激素。
SHPT是由肾小球滤过率(GFR)下降到50 ml/min/1.73 m²以下后的磷酸盐滞留引起的。第一个反应是FGF-23的分泌增加。随后,骨化三醇水平下降导致低钙血症,并引发PTH分泌增加。SHPT的严重程度随着肾功能的下降而增加。SHPT与骨转换紊乱和骨外钙化有关。骨骼重塑和矿化受损会导致继发性骨骼畸形。胸壁畸形和脊柱后侧凸是SHPT相关畸形的常见情况。然而,SHPT不仅限于骨骼表现,还影响终末期肾病(ESKD)患者的心血管死亡率。SHPT会引起各种骨骼外症状,如尿毒症瘙痒。
长期SHPT会导致纤维性骨炎(OFC),是由于慢性肾衰继发性甲状旁腺功能亢进,引起的高转运型骨病。甲状旁腺功能亢进导致皮质骨吸收、微骨折发展和骨组织出血。多核巨噬细胞迁移到该区域,导致肉芽组织向内生长。棕色瘤(BT)是一种罕见且严重的OFC。组织学上,BT表现为纤维组织和巨细胞的局部骨积聚。褐色是由于含铁血黄素沉积引起的。BT表现为局灶性骨病变,破骨细胞活性增加,小梁纤维化。
BT通常表现为骨骼中明确的病变,最常见于肋骨、锁骨、骨盆和下颌骨。尽管BT是良性骨病变,但在影像学上偶尔会表现为侵袭性恶性骨肿瘤。BT出现在眼眶骨的情况非常罕见,我们报告了一名长期透析的患者,患有难治性甲状旁腺功能亢进症,伴有体力障碍。
病例介绍
一名37岁的男子在过去的15年里每周接受三次血液透析(HD)治疗。在HD之前,他还接受了五年的腹膜透析。肾脏疾病的主要病因尚不清楚。患者因一个月渐进性右眼单侧前突和眼睑下垂就诊。
病人右眼单侧突眼,直接和间接瞳孔光反射正常。右眼可见有限的向上和向外凝视。右眼可见视神经乳头水肿和视盘肿胀,未发现异常神经反射。在他的身体其他部位没有发现任何肿块或淋巴结病。此外,左前臂可见动静脉瘘。患者未报告任何伴随症状,如晕厥、癫痫发作或大小便失禁。
磁共振成像(MRI)眼眶和颅骨检查发现在右眼眶后外侧一个眶外肿块。肿块压迫额骨眶部、右侧视神经和上直肌。病变尺寸为36*27*24mm,MRI表现出弥散均匀对比增强。肿瘤病变在T1加权图像上表现为轻微高信号,在T2加权图像上显示为低信号。MRI如图1所示。CT扫描显示,右侧眼眶后外侧有一个膨胀性肿块,伴有外周线性钙化,起源于蝶骨翼(图2)。肿块病变导致相邻骨结构侵蚀,被归类为BT。

图1 大脑MRI图像。黄色箭头指向右眶后上外侧位置的眶外肿块病变

图2 颅骨CT图像。箭头显示肿瘤病变伴周围线性钙化
实验室结果如下:葡萄糖:92 mg/dL,血尿素氮:56 mg/dL、肌酸酐:7.8 mg/dL;钠:137 mEq/L,钾:4.5 mEq/L;钙:9.7 mg/dL,血清25-OH维生素D:12 ng/mL,白细胞:9200/µL,血红蛋白:8.2 g/dL,血小板:390 × 10³/µL。患者接受了回肠手术、甲状旁腺切除术(具体不详)和腿部骨折手术病史(图3)。此外,患者多年来一直有肌肉无力和骨痛的症状。

图3 腿部的X射线照相术。黄色箭头显示胫骨动脉中的血管钙化,红色箭头显示胫骨上OFC
通过开颅手术切除了病变。手术过程中观察到肿块附近的硬脑膜完好。术后没有出现重大并发症。组织病理学检查标本支持BT的诊断,纤维骨病变包含巨细胞并伴有骨吸收。光学显微镜显示血管增加、成纤维细胞增殖、含有渗出红细胞的基质和破骨细胞型巨细胞(图4)。
图4 该图像显示了在光学显微镜下对肿瘤进行的病理检查
对患者进行甲状旁腺功能亢进评估,并用Tc-99间甲氧基异丁基异腈(MIBI)进行甲状旁腺闪烁扫描,发现三个不同的病灶与腺瘤一致。Tc-99 m MIBI的累积量大小在左甲状腺下方为25 × 14 mm,右甲状腺叶下方18 × 12mm,前纵隔区域12mm。颈部CT扫描对比进一步证实了这些发现。闪烁扫描图像如图5所示。

图5 甲状旁腺闪烁扫描在不同时间的图像。箭头指向腺瘤的位置
病情回顾
由于难治性甲状旁腺功能亢进,建议行甲状旁腺切除术,患者拒绝了手术。之后我们回顾性地调查了透析不足,并联系了透析科室。在过去的一年里,Kt/V大多低于1.2,而且他没有持续服用处方药。通过必要的调整提高了透析效率,在接下来的三个月里,平均Kt/V增加到1.7。患者在手术前接受肠外骨化三醇和司维拉姆治疗。患者先前因胃肠道副作用而拒绝口服西那卡塞,因此开始使用肠外西那卡塞。每周服用三次,每次最多7.5毫克。碳酸镧(每天3*1000 mg)、碳酸钙(每天3*2000 mg)和饮食磷限制治疗后磷含量降至目标范围(< 5.5 mg/dL)。在磷控制后,使用帕里骨化醇,每周三次,每次静脉注射10微克。随访显示PTH水平最低为1428 pg/mL。在最后一次实验室评估中,血清钙水平为10.4 mg/dL,甲状旁腺激素水平为2897 pg/mL,ALP为1204 IU/L。
医博士编译自: Uysal C, Yilmaz T, Ozkan H, Canoz O, Tokgoz B. The refractory secondary hyperparathyroidism presenting with retro-orbital brown tumor: a case report. BMC Nephrology. 2024;25(1):15. doi:10.1186/s12882-024-03455-8
声明: 所有注明“来源:医博士”的文字、图片和音视频资料,版权均属于医博士所有,转载须注明“来源:医博士”;所有转载文章系出于传递更多信息之目的,且明确注明来源和作者,不希望被转载的媒体或个人可与我们联系,我们将立即进行删除处理。